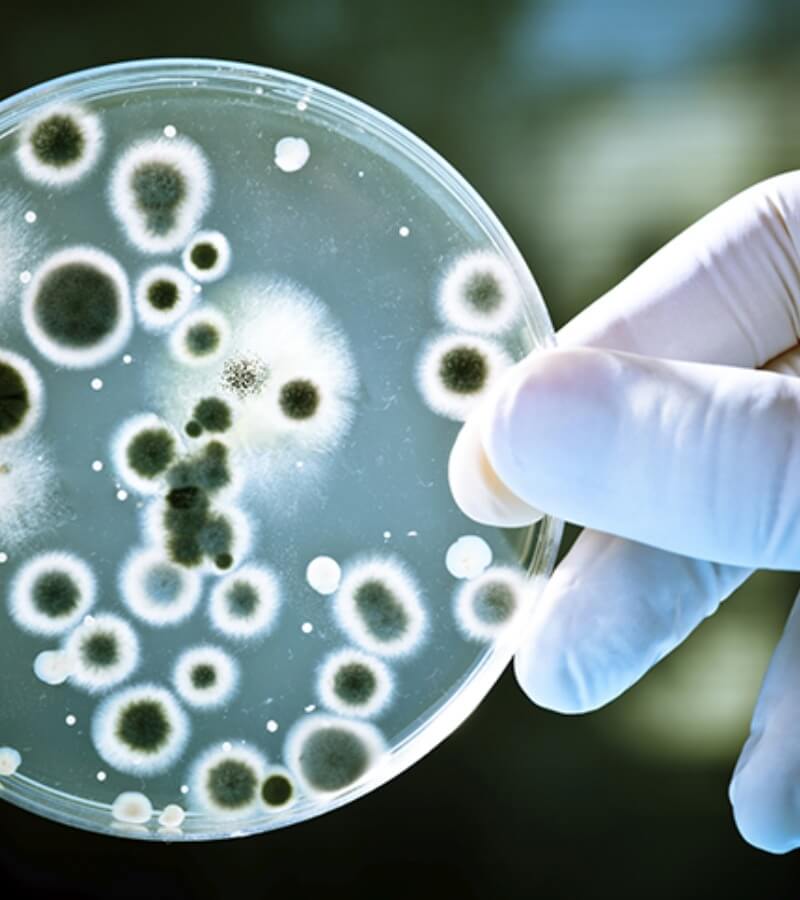
Nấm mốc gây bệnh gì_ _4

Nấm mốc gây bệnh là mối nguy tiềm ẩn trong nhiều gia đình, đặc biệt vào mùa nồm ẩm hoặc trong không gian kín thiếu thông thoáng. Không chỉ làm hư hại tường, trần và đồ nội thất, nấm mốc còn có thể phát tán bào tử vào không khí, ảnh hưởng trực tiếp đến hệ hô hấp, da và sức khỏe tổng thể.
Vậy nấm mốc gây bệnh như thế nào và đâu là giải pháp phòng ngừa hiệu quả, an toàn cho cả gia đình? Bài viết dưới đây sẽ giúp bạn hiểu rõ và chủ động bảo vệ không gian sống của mình.
Nấm mốc gây bệnh gì?
Nấm mốc gây bệnh theo nhiều cách khác nhau, đặc biệt trong môi trường ẩm ướt, kín gió hoặc vào thời điểm giao mùa. Khi độ ẩm tăng cao, các bào tử nấm phát tán trong không khí và dễ dàng xâm nhập qua đường hô hấp, da hoặc thực phẩm, từ đó ảnh hưởng trực tiếp đến sức khỏe.
Dưới đây là những nhóm bệnh phổ biến liên quan đến nấm mốc:
Bệnh hô hấp và dị ứng
Trong điều kiện bệnh do thời tiết ẩm hoặc bệnh do không khí ẩm, nấm mốc sinh sôi mạnh và trở thành tác nhân kích ứng đường thở. Việc hít phải bào tử nấm có thể gây:
- Hắt hơi, nghẹt mũi, ngứa mũi
- Ho kéo dài, khò khè
- Kích hoạt dị ứng thời tiết
- Làm trầm trọng hơn tình trạng viêm mũi dị ứng theo mùa
Vì vậy, vào mùa xuân hoặc mùa nồm, khi nấm mốc trong nhà mùa xuân xuất hiện nhiều ở tường, trần, phòng tắm…, nguy cơ bùng phát các bệnh hô hấp tăng rõ rệt. Đây cũng là lý do nấm mốc thường liên quan đến các dạng bệnh giao mùa và bệnh mùa nồm.
Bệnh ngoài da
Tiếp xúc trực tiếp với môi trường ẩm mốc có thể gây:
- Viêm da dị ứng
- Nổi mề đay
- Ngứa, phát ban
- Nấm da, nấm kẽ
Trẻ nhỏ, người cao tuổi và người có sức đề kháng kém là nhóm dễ bị ảnh hưởng nhất.
Ngộ độc thực phẩm do nấm mốc
Không chỉ tồn tại trong không khí, nấm mốc còn phát triển trên thực phẩm bảo quản kém. Một số chủng nấm có thể sinh ra độc tố (mycotoxin), gây:
- Rối loạn tiêu hóa: buồn nôn, tiêu chảy
- Ngộ độc cấp tính
- Ảnh hưởng gan, thận nếu tích lũy lâu dài
Đáng chú ý, một số độc tố nấm có khả năng tồn tại ngay cả khi thực phẩm đã được nấu chín, vì vậy việc sử dụng thực phẩm bị mốc tiềm ẩn nhiều rủi ro.
Tóm lại:
Nấm mốc gây bệnh không chỉ dừng lại ở các triệu chứng dị ứng nhẹ mà còn có thể ảnh hưởng sâu đến hệ hô hấp, da và thậm chí là nội tạng nếu tiếp xúc kéo dài. Trong điều kiện khí hậu nóng ẩm, đặc biệt vào mùa nồm hoặc giai đoạn chuyển mùa, việc kiểm soát độ ẩm và xử lý môi trường sống là yếu tố then chốt để phòng ngừa hiệu quả.
Biện pháp chống nấm mốc gây bệnh hiệu quả
Để hạn chế nấm mốc gây bệnh, đặc biệt trong giai đoạn chuyển mùa – thời điểm dễ phát sinh bệnh giao mùa, bệnh mùa nồm hay các dạng bệnh do thời tiết ẩm, cần kết hợp xử lý môi trường sống và kiểm soát chất lượng không khí trong nhà.
Dưới đây là những giải pháp quan trọng:
Kiểm soát độ ẩm trong không gian sống
- Kiểm tra và xử lý ngay các vị trí rò rỉ nước ở mái nhà, tường, đường ống.
- Giữ khu vực phòng tắm, nhà bếp luôn khô ráo, lau sạch nước đọng mỗi ngày.
- Tăng cường thông gió tự nhiên hoặc lắp quạt thông gió để giảm bệnh do không khí ẩm.
- Hạn chế sử dụng thảm, rèm vải dày – những vật liệu dễ giữ ẩm.
- Phơi quần áo dưới nắng thay vì hong trong phòng kín.
- Định kỳ vệ sinh điều hòa để tránh tích tụ vi khuẩn và nấm mốc trong nhà mùa xuân.
- Có thể sử dụng giấm trắng, baking soda hoặc dung dịch chuyên dụng để làm sạch vùng tường mốc.
Việc giữ nhà cửa khô thoáng giúp giảm nguy cơ kích hoạt dị ứng thời tiết, hạn chế bùng phát viêm mũi dị ứng theo mùa và các vấn đề hô hấp liên quan.
Phòng ngừa nấm mốc trong thực phẩm
- Bảo quản thực phẩm khô ở nơi thoáng mát, tránh ánh nắng và độ ẩm cao.
- Đóng kín bao bì sau khi sử dụng, cân nhắc bảo quản lạnh tùy loại thực phẩm.
- Loại bỏ ngay thực phẩm có dấu hiệu đổi màu, mùi lạ hoặc xuất hiện đốm mốc – không nên cắt bỏ phần mốc để dùng tiếp.
- Nếu có dấu hiệu nghi ngờ ngộ độc sau khi ăn thực phẩm ẩm mốc, cần ngừng sử dụng và đến cơ sở y tế kịp thời.

Giải pháp chủ động: Lọc sạch không khí và cấp khí tươi AC-160
Trong điều kiện khí hậu nóng ẩm, chỉ thông gió tự nhiên là chưa đủ để kiểm soát hoàn toàn nấm mốc gây bệnh. Thiết bị cấp khí tươi kết hợp lọc bụi chuyên sâu như AC-160 giúp xử lý đồng thời nhiều vấn đề:
Cấp khí tươi đã lọc sạch
Không khí từ bên ngoài được đưa vào máy và đi qua 4 lớp lọc trước khi cấp vào phòng. Nhờ đó, khí đưa vào không chỉ giàu oxy mà còn được loại bỏ bụi và tạp chất. Nồng độ CO₂ luôn được duy trì dưới 1000ppm – mức an toàn cho sức khỏe, giúp không gian thông thoáng, giảm cảm giác bí bách mùa nồm.
Lọc bụi siêu mịn và bào tử nấm mốc
Cấu trúc lọc dạng tháp nhiều tầng giúp giữ lại bụi lớn trước, sau đó xử lý bụi mịn và siêu mịn.
- Lọc tới 99,99% hạt PM0.3 (đo kiểm thực tế bằng máy đo tiểu phân CEM).
- Hạn chế phát tán bào tử nấm – yếu tố làm trầm trọng các bệnh hô hấp và bệnh do thời tiết ẩm.
Sưởi ấm không khí khi trời lạnh
Bộ sưởi gốm PTC làm ấm luồng khí trước khi vào phòng, không gây khô da, phù hợp mùa đông – thời điểm dễ phát sinh bệnh giao mùa.
Hệ thống lọc dày và bền bỉ
- Lọc thô inox chống gỉ (có thể rửa định kỳ).
- Lọc trung cấp F9 (xuất xứ Phần Lan) giữ phần lớn bụi mịn.
- Lọc HEPA H13/14 (Mỹ) loại bỏ 99,99% bụi siêu mịn PM0.3.
- Lọc than hoạt tính (Canada) giúp khử mùi và khí độc.
Bộ lọc dày giúp tăng hiệu quả giữ bụi và kéo dài tuổi thọ sử dụng.
Vận hành êm ái – phù hợp phòng ngủ
- Động cơ EBM Papst (Đức), tuổi thọ cao, không cần tra dầu trong thời gian dài.
- Độ ồn chỉ khoảng 22–29dB, gần như không ảnh hưởng giấc ngủ.
- Có 5 mức trộn gió (0–100%) hoặc chế độ tự động để điều chỉnh lượng khí tươi linh hoạt.

>>>Xem thêm: Review máy lọc không khí SmartVent AC-160 3in1 của AirProce chi tiết từ A-Z
FAQ
1. Vì sao nấm mốc gây bệnh dễ bùng phát vào mùa nồm hoặc giai đoạn chuyển mùa?
Vào thời điểm độ ẩm không khí tăng cao, đặc biệt trong mùa nồm hoặc khi thời tiết thay đổi đột ngột, môi trường ẩm ướt tạo điều kiện lý tưởng cho bào tử nấm phát triển và phát tán. Đây cũng là lúc các bệnh giao mùa, dị ứng thời tiết và vấn đề hô hấp dễ xuất hiện hơn.
2. Làm thế nào để nhận biết trong nhà đang có nguy cơ nấm mốc gây bệnh?
Một số dấu hiệu thường gặp gồm: tường, trần xuất hiện đốm đen hoặc mùi ẩm mốc; không khí trong phòng bí, nặng mùi; các thành viên trong gia đình thường xuyên hắt hơi, nghẹt mũi, ho kéo dài hoặc tái phát viêm mũi dị ứng theo mùa khi ở trong nhà.
3. Chỉ mở cửa thông gió có đủ để phòng ngừa nấm mốc gây bệnh không?
Thông gió tự nhiên giúp giảm ẩm phần nào nhưng chưa thể loại bỏ hoàn toàn bào tử nấm, bụi mịn và khí ô nhiễm trong không khí. Để kiểm soát hiệu quả hơn, nên kết hợp giữ nhà khô thoáng, vệ sinh định kỳ và sử dụng thiết bị lọc – cấp khí tươi nhằm duy trì môi trường sống sạch, giàu oxy và an toàn cho sức khỏe.
Kết:
Trên đây là toàn bộ thông tin hữu ích về nấm mốc gây bệnh. Nếu bạn vẫn còn phân vân chưa biết có nên mua máy lọc không khí hay không, hãy liên hệ ngay đến hotline 0965.356.499 để được tư vấn hoàn toàn miễn phí.
>>>Xem thêm: Lý do khiến viêm mũi dị ứng theo mùa thường xảy ra
